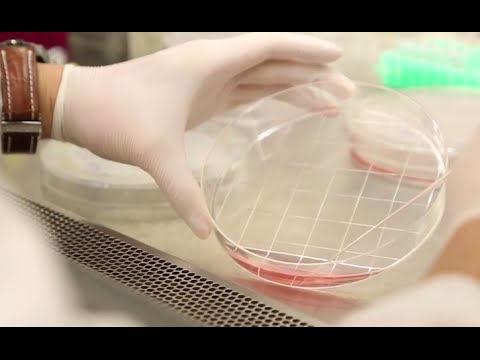
Understanding EIRB: Key Principles and Applications

You know how life feels like a rollercoaster sometimes? One minute you’re on top of the world, and the next, you’re looping upside down. Well, research can be a bit like that too.
Este blog ofrece contenido únicamente con fines informativos, educativos y de reflexión. La información publicada no constituye consejo médico, psicológico ni psiquiátrico, y no sustituye la evaluación, el diagnóstico, el tratamiento ni la orientación individual de un profesional debidamente acreditado. Si crees que puedes estar atravesando un problema psicológico o de salud, consulta cuanto antes con un profesional certificado antes de tomar cualquier decisión importante sobre tu bienestar. No te automediques ni inicies, suspendas o modifiques medicamentos, terapias o tratamientos por tu cuenta. Aunque intentamos que la información sea útil y precisa, no garantizamos que esté completa, actualizada o que sea adecuada. El uso de este contenido es bajo tu propia responsabilidad y su lectura no crea una relación profesional, clínica ni terapéutica con el autor o con este sitio web.
Imagine trying to figure out how people change over time. It’s not just about snapshots; it’s about the whole journey. That’s where longitudinal surveys come in! They track folks over months or even years.
So what’s the deal? These surveys help researchers understand how things evolve. Think about health, relationships, or habits. It’s all connected!
Stick around as we take a closer look at how these surveys work and why they matter. You might find it way more interesting than you expected!
Advantages of Longitudinal Studies for Measuring Behavioral Changes Over Time
Longitudinal studies are like that one friend who sticks around to see how your life changes over the years. They involve repeated observations of the same variables over a long period of time, which is super helpful for understanding behavioral changes. Let’s break down some advantages of these studies in a casual way, shall we?
1. Capturing Change Over Time
One of the biggest perks is that longitudinal studies let researchers track changes more effectively than, say, a snapshot study. Imagine watching the same player level up in a game over several seasons versus just checking in on how they did last week. You’re getting the full picture!
2. Establishing Cause and Effect
Because you’re gathering data on the same subjects over time, it’s easier to figure out what causes what. If you notice someone’s behavior towards certain games or experiences shifting as they age or after specific events—like transitioning schools—you can pinpoint factors that might have influenced those changes.
3. Richer Data Collection
Having multiple points of data allows for deeper insights. Instead of just knowing that someone likes action games now, you could analyze how their preferences shifted from strategy games to action over the years—and why! This kind of information can reveal trends and patterns that one-time surveys totally miss.
4. Individual Differences
Everyone evolves differently! Longitudinal studies shine when it comes to showcasing how different individuals respond to similar experiences or challenges. For instance, two friends might start gaming together but end up gravitating toward different genres based on their life choices or stress levels.
5. Flexibility with Time Frames
You can choose how long your study lasts depending on what you’re looking for! Some researchers may want to observe a few months, while others might stick around for decades, like dedicated fans waiting for a game sequel.
6. Understanding Developmental Processes
These studies help illustrate different stages of growth or change in behavior across generations or developmental phases—like childhood vs adolescence vs adulthood in gaming habits or interests.
But here’s what you gotta remember: while longitudinal studies provide incredibly useful insights into human behavior and development, they don’t replace professional help if someone needs it. Observing change is great, but sometimes those changes need expert guidance too.
All things considered, longitudinal studies are pretty cool tools in research! They help us unravel the complexities behind behavioral shifts over time rather than giving us just bits and pieces of information here and there. So next time you think about why you’ve changed your game preferences or how your personality has evolved—there’s probably some intriguing research backing it up!
Exploring Two Key Limitations of Longitudinal Research in Psychology
Longitudinal research in psychology can feel like tracking a game’s progress level by level. You’re looking at changes over time, which is super cool for understanding development or behavior shifts. But, hey, it’s not all smooth sailing. There are some serious limitations to keep in mind.
First Limitation: Time and Cost
Longitudinal studies take a lot of time! Imagine playing a game that spans several years, where you have to come back to it regularly. Researchers need patience and resources because they gather data from the same group repeatedly over long periods. This means you end up spending loads on funding, staff, and resources. It’s like investing in an epic quest but sometimes not seeing the treasure for ages!
Second Limitation: Participant Dropout
Another hiccup? People drop out! You know how in some games, you lose players who just stop showing up? In longitudinal studies, this happens too—whether due to life changes or just lost interest. This dropout can skew results and make it tough to generalize findings. If key players leave mid-game, how do you assess the final score?
To sum it up:
- The time and cost involved can limit the number of studies researchers can conduct.
- Participant dropout may compromise the validity of findings.
For example, think about a study tracking children’s development from birth to adulthood. If some kids leave the study early due to family moves or other factors, conclusions about growth patterns could be off base.
In the end, while longitudinal research offers incredible insights into psychological changes over time—like leveling up through different stages of life—it does come with its share of challenges that researchers must navigate carefully!
Understanding Longitudinal Studies: Tracking Behavioral and Mental Process Changes Over Time
Longitudinal studies are like the slow cooker of research! Instead of just capturing a quick snapshot, these studies track people over a long period. This method helps researchers understand how behaviors and mental processes change over time.
So, what’s the big deal? These studies are super valuable because they show patterns that might not be obvious in short-term research. Imagine trying to see how someone’s mood shifts after playing a challenging video game for a month. If you only check in once, you might miss those critical ups and downs throughout the experience.
Here’s why longitudinal studies matter:
- Tracking Change: They help us see shifts in attitudes or behaviors across time. For instance, maybe someone who was shy at twelve becomes more outgoing by sixteen. That kind of transformation can be revealing.
- Causation vs. Correlation: Long-term tracking allows researchers to figure out what comes first—like whether playing an online game boosts social skills or if outgoing people just tend to enjoy games more.
- Understanding Lifespan Development: These studies give insight into various life stages, helping us understand childhood development through adulthood and even into older age.
- Identifying Influences: By observing changes over time, researchers can identify factors that influence behaviors—like how family support impacts mental health during adolescence.
Let’s say you’re studying how video games affect problem-solving skills. You could check in with participants every few months about their gaming habits and their scores on problem-solving tests. If someone starts playing strategy games regularly, you might notice improvement in their scores as time goes by.
Anecdote time! Picture this: There was once a study on kids who played collaborative games versus solo ones. Over two years, researchers found that kids who played team-based games developed better communication skills compared to those who didn’t. It was kind of amazing to see how ongoing interaction shaped their behavior!
But here’s the kicker—longitudinal studies do take a lot of time and effort. Participants have to commit for years! Plus, there are challenges like keeping track of them as life happens: people move away or drop out entirely.
In the end, while longitudinal studies are powerful tools for understanding human behavior and mental processes over time, they also require patience—kind of like waiting for that perfect meal from the slow cooker!
It’s important to remember though: if you’re feeling overwhelmed or struggling with your thoughts or behaviors, reach out for professional help! Longitudinal studies can offer insights but cannot replace personalized support tailored just for you.
You know when you think back on your life and wonder how you’ve changed? Like that moment in high school when you were desperately trying to fit in, and now you look back and chuckle at those awkward hairstyles? Well, that’s kind of what a longitudinal survey does, but for research!
A longitudinal survey is a study that observes the same subjects over a period of time. It’s like taking snapshots of people’s lives at different stages. This method helps researchers see how things evolve, whether it’s health, behaviors, or even opinions. You get to watch people grow and change (or not!) over the years. Pretty cool, right?
I remember reading about a study where researchers followed a group of kids from kindergarten all the way into adulthood. They tracked everything from academic performance to social skills. Isn’t it wild to think how those tiny little humans would grow up into adults with dreams and challenges? It gives you this incredible insight into life transitions.
Now picture trying to figure out if eating breakfast actually helps your grades by just looking at kids for one year. I mean, what if they had a rough year? Or maybe they changed schools and got totally distracted by new friends? Longitudinal surveys take away some of that guesswork because they show patterns over time instead of just snapshots.
But it’s not all sunshine and rainbows; there are challenges too! Keeping track of folks for years can be tricky. People move away or drop out for various reasons—life happens! Plus, there can be changes in researchers or measurement methods along the way that might impact the data.
To wrap it up, long-term surveys give us this golden opportunity to connect the dots in human behavior. So next time someone asks you about why tracking changes is important in research, just think about how every little moment counts—and how we all evolve over time, like those high school hairdos!